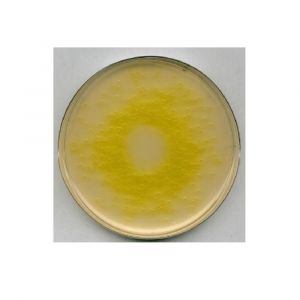
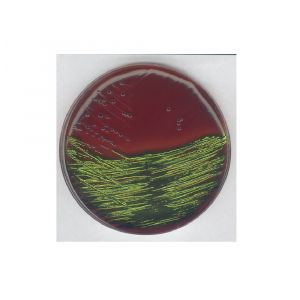
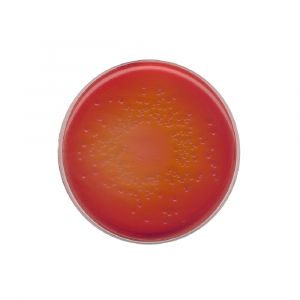
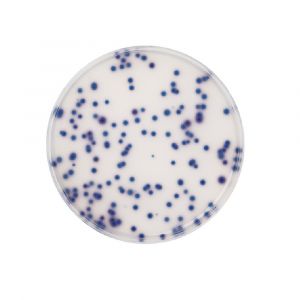

Agares
Agar para Microbiología: Cultivos Precisos y Confiables para tu Laboratorio
Explora nuestra selección de agar de primera calidad, tu aliado fundamental en microbiología. Nuestros productos ofrecen el entorno de cultivo óptimo para el crecimiento bacteriano, garantizando resultados precisos en cada análisis. Desde agares nutritivos hasta variantes selectivas, nuestra amplia gama satisface las necesidades de laboratorios, industria alimentaria y farmacéutica. Confía en la excelencia de nuestros agares para potenciar tus investigaciones microbiológicas. Diseñados para cumplir con los estándares más rigurosos, nuestros productos aseguran la calidad que tu laboratorio demanda, proporcionando resultados confiables en cada paso de tu trabajo científico.